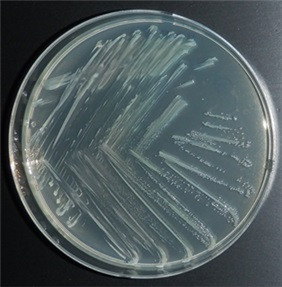

|
국립해양생물자원관 연구진 도다리에서 항균 및 피부탄력 유지개선에 탁월한 유산균 발견
프로바이오틱스, 발효용 스타터, 항균제, 화장료 원료로 가능 등 특허 2건 출원
영남도민일보 기자 / yndm1472@nate.com 입력 : 2023년 08월 01일(화) 19:41
공유 :   
|
|
|  | | | ⓒ (주)영남도민일보 | [영남도민일보] 영남도민일보 기자 = 국립해양생물자원관(관장 최완현)은 어류인 도다리의 장(腸)에서 신규 유산균을 발굴하고 생균제, 발효용 스타터, 항균제 및 화장료 원료 등에 활용이 가능한 효능을 찾아 특허 출원(2건)*을 완료했다고 1일(화) 밝혔다. * ➀ 신규 라티락토바실러스 사케이 아종 사케이 M21F010 균주 및 이의 용도 ➁ 신규 라티락토바실러스 커바투스 M21F011 균주 및 이의 용도
유산균*은 당을 이용하여 젖산**을 생성하는 젖산균(lactic acid bacteria)으로 인체 건강기능 증진 효과로 상용화된 미생물로 알려져 왔다. 그러나 장 건강 기능증진에 초점을 맞춰 왔던 과거와 달리 최근엔 피부, 다이어트, 스트레스 관리 등의 기능성 유산균 개발과 장내 마이크로바이옴 기반의 인체 질병 개선, 면역력 증강 등 건강기능식품을 넘어 의약품 분야로 활용 범위가 확대 ․ 세분화 되면서 학계, 산업계 및 소비자에게 관심이 집중되고 있다. * 2002년 국제식량농업기구(FAO)와 세계보건기구(WHO)에서 ‘적절한 양을 섭취하였을 때 숙주(사람 등)의 건강에 도움을 주는 유익한 생균’으로 정의 ** ‘우유’를 뜻하는 라틴어에서 유래되었으며 젖산, 유산, 락트산으로도 불림. 유산균에 다량 내포하고 있는 유기산 중 하나로 의약, 식품, 사료 및 화장품 등 다양한 분야에서 항균제, 산도조절제, 향미증진제, 각질제거제, 피부재생 등 다양한 역할로 사용되고 있음. 국립해양생물자원관 미생물자원실 연구진은 장(腸) 내에서 우수한 내산성, 내담즙성, 비용혈활성 특성을 가진 유산균 후보 2종을 찾아 내었다.
연구진은 농도별 배양액(발효액)을 사용하여 병원균에 대한 뛰어난 항균활성과 항산화, 미백, 주름개선 등의 효과를 밝혀내고 장내 유해균 성장 억제와 유익균 성장을 도와주는 유기산 함량 향상의 최적 배양조건을 확립하였으며 피부 탄력 유지에 유용한 콜라겐(collagen)을 분해하는 콜라게나제(collagenase)의 저해 능력은 희석 농도와 무관하게 모든 시료에서 뛰어난 강한 활성을 보여주고 있음을 확인하였다.
국립해양생물자원관 최완현 관장은“세계적인 웰빙 트랜드와 인구 고령화로 건강에 대한 관심이 증가함에 따라 국내 유산균 수요도 꾸준히 증가하고 있는 추세(전년 대비 8%)에 따라 이번 해양 유래의 유산균은 기능성 프로바이오틱스 시장에 단비와 같은 기술로, 향후 상용화로 연계된다면 인체의 장 건강과 동시 피부 탄력 유지 및 개선에 큰 도움이 될 것으로 기대한다.”고 말했다.
|
|
|
영남도민일보 기자 yndm1472@nate.com - Copyrights ⓒ(주)영남도민일보.
무단 전재 및 재배포 금지 -
|
|
|
|
|
|
|
|
|
실시간
많이본
뉴스
|
|
|
|
최신뉴스
|
|
|
사하소방서, 현장대응역량 강화를 위한‘전술배연 교육’실시.. |
경남교육청, 2026년 교육공무직원 업무 담당자 연수 개.. |
2026학년도 영주기초학력거점지원센터 1학기 교원 역량 .. |
예천소방서, 봄철 ‘특수시책’ 분사호스세트 설치로 산불.. |
구미경찰, 어르신 대상 안전띠 매기, 안전모 쓰기 교통안.. |
경산경찰서, 1억7천만 원 보이스피싱 막은 농협 은행원 .. |
영주경찰서, 자율방범대와 협력 치안으로 지역 안전 강화.. |
영주소방서, 영주시와 함께 ‘불NO! 장생 프로젝트’ 합.. |
경상북도교육청 봉화도서관 이전 신축, 문체부 ‘설립타당성.. |
영주시의회, 2026년 제1회 청소년의회 운영.. |
국립산림치유원, 경북도·영주시와 함께 산불 피해지역 주민.. |
노벨리스 영주공장&봉사대 후원, 연화보호작업장 장애인 .. |
경북도민행복대학 영주시캠퍼스 ‘1학기 현장교육’ 성료.. |
영주시, 청소년안전망 청소년복지 심의위원회 개최.. |
영주시, 산불 예방을 위한 ‘불NO! 장생 프로젝트’ 합.. |
|